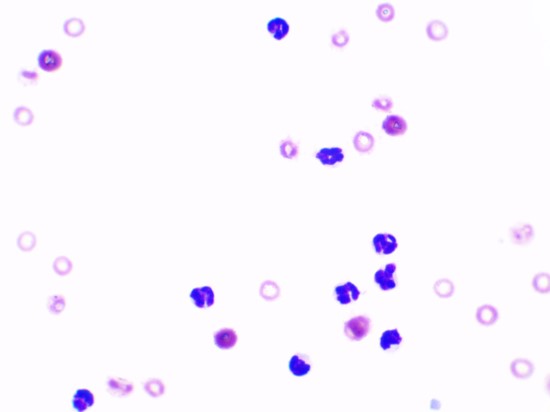

면역 매개성 다발성 관절염
6년령 중성화한 수컷 믹스 강아지가 3개월 전부터 눕거나 앉아 있다가 일어설 때 우측 후지를 불편해 하는 증상으로 내원했다.
타원에서 방사선, MRI 촬영 등 검사 진행 하였지만 뚜렷한 원인을 찾지 못했고, 진통소염제 복용 시 약간의 증상 개선을 보이지만 완벽하게 개선되지 않고, 내원 며칠 전부터 양측 뒷다리 발목 주변으로 원인 불명의 부종이 발생한 경력이 있었다.
내원 당시 식욕 및 활력 양호하였으며 신체검사 상에서도 뚜렷한 통증 반응은 없고, 우측 무릎 관절 및 양측 후지 발목 관절 주변의 경미한 부종 외에는 특이사항 없었다.

기본적인 혈액 검사 상 염증수치(CRP) 상승 외에는 혈액검사 상에서 특이사항은 확인되지 않아, 지속적인 염증 수치 상승 시 추가 검사를 실시하기로 하였고, 2개월 뒤 재검 시에도 뚜렷한 염증 수치 상승이 지속되어 관절낭 천자를 실시하였다.

관절 천자는 우측 뒷다리 무릎관절과 좌측 뒷다리 발목 관절에서 진행하였으며 검사 결과 관절액의 점성 저하와 현미경 상 감염체는 확인되지 않으나, 백혈구의 한 종류인 호중구가 90%이상 차지하는 화농성 관절염이 진단되었다.
결과적으로 환자의 후지 파행의 원인은 화농성 관절염으로 확인되었다. 화농성 관절염의 원인으로는 감염성, 반응성, 원발성이 있으며 전반적인 검사 상에서 관절 및 전신 감염이 확인되지 않았기 때문에 원발성(특발성) 면역매개성 다발성 관절염으로 진단되었다.
면역 매개성 다발성 관절염(IMPA) 이란?
면역 매개성 다발성 관절염 (IMPA)란, 여러 관절에서 호중구성 염증이 관찰되는 질환이다.
임상 증상으로는 파행, 경직, 걷기를 싫어하는 행동과 일부 환자에서는 식욕저하, 고열 등의 전신증상이 나타나기도 한다. 원인으로는 감염성, 반응성, 원발성으로 구분된다. 진단은 혈액검사, 근골격계 방사선 검사, 신체검사, 관절액 검사 등을 통해서 이루어집니다. 전신 홍반성 루프스 (SLE), 류마티스 관절염과 추가적인 감별이 필요하다.
치료 및 예후는, 감염성과 반응성의 원인이 모두 아닐 때 진단이 가능하며 면역억압 치료에 양호한 반응을 보이지만, 일부 환자에서는 치료 중 또는 종료 이후에 질병이 재발 할 수 있다.
치료 경과
앞서 면역매개성 다발성 관절염을 진단받은 환자는 스테로이드 및 이차 면역억압제 투여 2주 후부터 이전에 보였던 우측 후지의 불편한 증상과 관절 주변의 부종이 모두 사라졌으며 활동량도 평소보다 증가되었다. 혈액검사 상에서 상승하였던 염증수치도 정상화되었다. 이 후 2주 간격으로 스테로이드 감량 중에 있으며 현재까지는 증상 재발 없이 잘 유지되고 있다.
본동물의료센터에서는 뚜렷한 원인 없이 다리를 불편해 하는 환자에서 관절염 진단을 위한 관절 천자 및 관절액 검사를 모두 진행하고 있다.
관절천자는 경우에 따라 전신 마취가 필요한 시술로 본 동물의료센터에서는 호흡 마취를 통한 안전하고 정확한 검사가 가능하다. 2차동물병원으로서 다수의 약물 보유를 통한 다양한 치료 옵션을 제공 할 수 있으며 24시간 진료를 통해서 갑작스러운 부작용 증상에도 빠르게 대처할 수 있다.

본동물의료센터는
24시간 중환자 관리 시스템을 갖춘 2차동물병원으로
중증 질환을 가진 동물들을 치료하고 있습니다.
모두가 자고 있는 새벽에도
본동물의료센터 의료진들은 아픈 아이들을 돌보며 치료를 이어가고 있습니다.
모든 아이들이 아픔을 떨쳐내고, 다시 가족의 품에 돌아갈 수 있도록
끊임없이 노력하겠습니다.
▶ 안양본동물의료센터 오시는 길(클릭)

















































































































































